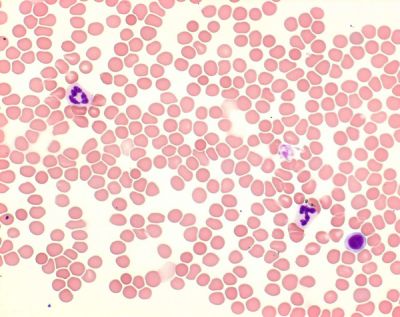
Giemsa azur eozin metilen mavisi çözeltisi mikroskopi için. 500 ml

Giemsa azur eozin metilen mavisi çözeltisi mikroskopi için. 500 ml

KDV DAHİL
:
26,40 EUR1.404,77 TL
Not
:
kimeksonline.com ödeme bilgilerinizi güvende tutar. Ödeme esnasında kredi kartı bilgileriniz hiçbir şekilde 3. kişiler tarafından görünmemektedir.
![]()
- Ürün Özellikleri
- Ödeme Seçenekleri
- Yorumlar (0)
- Tavsiye Et
- Resimler
- Beni Ara
- Hızlı Mesaj
- Öneri Kutusu
-
Mikroskopi için. Kan ve kemik iliği yaymalarının, parafin kesitlerinin ve klinik-sitolojik örneklerin boyanması için.
Genel açıklama
Giemsa'nın Azure Eosin Metilen Mavisi çözeltisi - mikroskopi için, kan ve kemik iliği yaymalarının, parafin kesitlerinin ve klinik-sitolojik örneklerin boyanmasında kullanılabilir. Giemsa boyama, histolojide standart prosedürlerden biridir ve çeşitli hücreleri morfolojik özellikleriyle H&E boyasından daha iyi gösterir. Hematolojik uygulamalarda kullanıldığında, Giemsa boyası sıklıkla diğer boyama çözeltileriyle, örneğin Pappenheim (MGG) genel görünüm boyaması için May-Grünwald çözeltisiyle birlikte kullanılır. Bu kullanıma hazır boyama çözeltisi, genellikle eosin Y boyası ile Azure B-DNA kompleksi arasındaki moleküler etkileşime dayanarak çekirdekleri kırmızıya boyar. Her iki boya da Eosin Y - Azure B-DNA kompleksi oluşturur ve oluşan boyanın yoğunluğu Azure B içeriğine ve Azure B : Eosin Y oranına bağlıdır. Ayrıca, oluşan boya, fiksasyonun, boyama sürelerinin, çözeltilerin pH değerinin veya tampon maddelerin etkisine bağlı olarak değişebilir. Histoloji ve klinik-sitolojik uygulamalarda, ek boyama yapılmadan Giemsa boyaması, genişletilmiş genel bir boyama yöntemi olarak kullanılır. Bu yöntemde, çeşitli hücre bileşenlerinin rengi, numune materyalinin ön işleminden etkilenir. Burada, kromatin içeren yapılar (örneğin hücre çekirdekleri) çeşitli mavi tonlarında görünürken, asidofilik bileşenler çeşitli kırmızı tonlarında görünür. 500 ml'lik şişe 3500-5000 boyama için yeterlidir. Bu ürün IVD olarak kayıtlıdır ve CE işareti taşımaktadır.Teslimat Bilgisi:hafta içi saat 16:00 'dan önce vermiş olduğunuz siparişleriniz aynı gün kargoya verilmekte ve kargonun gönderileceği şehre bağlı olarak Yurtiçi Kargo tarafından 1-3 iş günü içinde teslim edilmektedir.Ürün Etiketlerigiemsa's azur eosin methylene blue solution , methylene blue , methylene blue merck , giemsa stain , merck millipore , merck manual , merck serono , merck türkiye , merck türkiye bayileri , merck türkiye sat?? , medica , hastanede gerekli malzemeler , metilen mavisi , eozin metilen mavisi , metilen mavisi satan firmalar
Tavsiye Edilenler
Seçilenleri karşılaştır